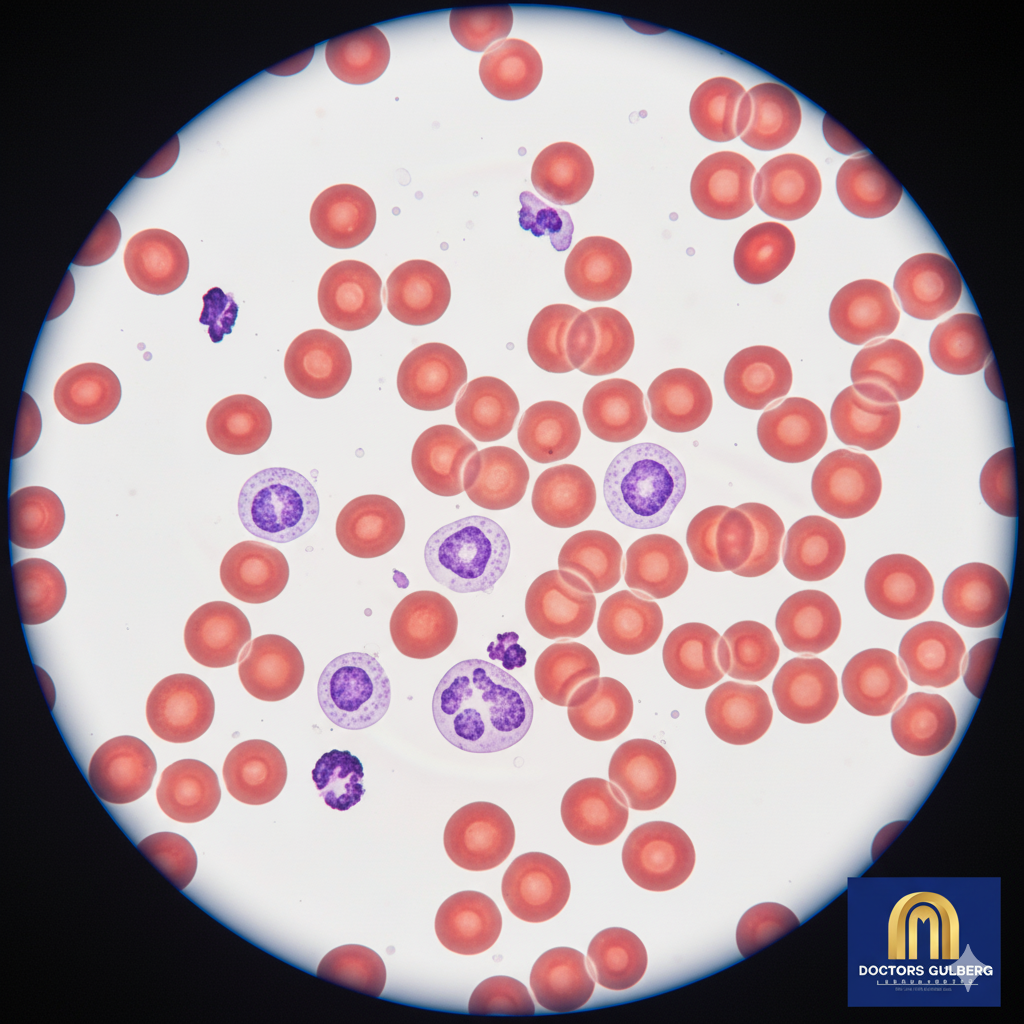
Standard View

Why Choose Us?
Certified Quality
PHC & CPSA Certified, ensuring international standards.
Advanced Technology
State-of-the-art equipment for maximum accuracy.
Patient-Centric Care
Compassionate service and convenient home sampling.
Fast & Reliable
Timely, accurate results you and your doctor can trust.
Our Numbers By Fact
Years of Experience
Since 2003
Diagnostic Accuracy
Verified by external quality assurance
Tests Performed
Serving thousands of patients annually
Our Core Values
Precision
Every test, every time. Accuracy is not just a goal, it's our guarantee.
Integrity
We uphold the highest ethical standards, ensuring patient confidentiality and trust.
Innovation
Continuously investing in the latest technology to provide better, faster results.
Our Journey of Excellence
Our Technology

Molecular Analyzers
Cutting-edge platforms for high-sensitivity testing.
Digital Microscopy
Drag to see AI-assisted imaging in action.

Robotic Automation
Ensuring precision and rapid turnaround times.
Meet Our Leadership
Dr. Zahid Zia
Pathologist
Laiba Ilyas
Incharge Operations
Atiqa Malik
Incharge Patient Relations
Abdul Basit
Incharge Home Sampling
Mr. Afaq
Supervisor Home Sampling
Shahla Amir
Senior Technologist
What Our Partners Say
"DGL is our trusted partner for all our diagnostic needs. Their results are reliable, their turnaround is fast, and their team is always professional. They are a benchmark for quality in the city."
Dr. Aisha Khan
Consultant Physician
"The home sampling service is a game-changer for my elderly patients. It's convenient, safe, and the staff are incredibly compassionate. I highly recommend Doctors Gulberg Laboratories."
Dr. Rizwan Ahmed
Senior Medical Officer
"As a surgeon, I need fast, accurate pre-op testing. DGL delivers every single time. Their advanced technology gives me the confidence I need to proceed with complex procedures."
Dr. Fatima Jilani
Consultant Surgeon
Our Mission
To be the region's most trusted diagnostic laboratory by committing to the highest standards of quality, embracing technological innovation, and providing compassionate care to every patient we serve.
We strive to empower healthcare providers and patients with the accurate, timely information they need to make the best health decisions.
Frequently Asked Questions
What are your lab timings?
Our main laboratory is open 24 hours a day, 7 days a week for sample collection and processing. Our patient service centers have separate timings, please check our 'Locations' page for details.
How do I book a home sample collection?
You can book a home sample collection easily by calling our dedicated helpline at [Your Phone Number], or by filling out the online booking form on our website. Our team will coordinate a convenient time with you.
How long does it take to get my results?
Turnaround time varies depending on the test. Most routine test results are available online within 4-6 hours. Specialized tests, like molecular or cultures, may take longer. Your phlebotomist will provide you with an estimated time.
Are you certified?
Yes, we are proud to be certified by both the Punjab Healthcare Commission (PHC) and the College of Physicians and Surgeons Pakistan (CPSA). This ensures our processes meet rigorous international quality standards.